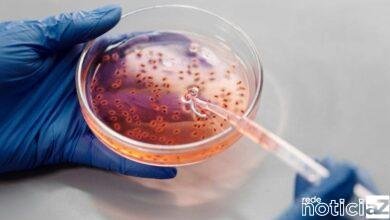
Vacina anticâncer é desenvolvida e gera esperança

CANADÁ
-

-
 15 de junho de 20220
15 de junho de 20220Ator mata a mãe e revela que tinha planos para matar primeiro-ministro do Canadá
-
 12 de janeiro de 20220
12 de janeiro de 20220Província do Canadá vai cobrar “imposto” para quem não se vacinou contra a Covid-19
-
 27 de outubro de 20210
27 de outubro de 20210Países começam a emitir primeiros passaportes para pessoas não binárias
-
 30 de junho de 20210
30 de junho de 20210O calor toma conta do Canadá e provoca mortes súbitas
-
 25 de maio de 20210
25 de maio de 20210Vacina anticâncer é desenvolvida e gera esperança
-
 5 de fevereiro de 20210
5 de fevereiro de 20210Cinema mundial perde Christopher Plummer